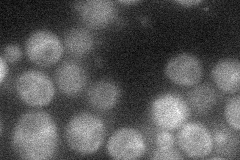
YNL265C
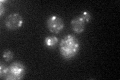
YNL265C

View description
Protein with a positive role in the multivesicular body sorting pathway; functions and forms a complex with Did2p; recruitment to endosomes is mediated by the Vps2p-Vps24p subcomplex of ESCRT-III; also interacts with Vps4p
Localization:
Intensity:
Fold change:
Significance:
-
C’ GFP library in SD

punctate40.88 -
N' NOP1pr-GFP in SD
cytosol22.4873 -
N' TEF2pr-mCherry in SD

punctate35.2925 -
N' NATIVEpr-GFP in SD

below threshold23.5025 -
N' TEF2pr-VC and Cyto-VN in SD

cytosol38.8681 -
C’ GFP library in SD+DTT

punctate42.971.05No -
C’ GFP library in SD+H2O2

punctate47.331.15No -
C’ GFP library in Starvation Media
punctate46.441.13No -
C’ GFP library on the background of Pup2-DaMP

punctate -
C’ GFP library on the background of CCT mutant

punctate36.81440.900279No
